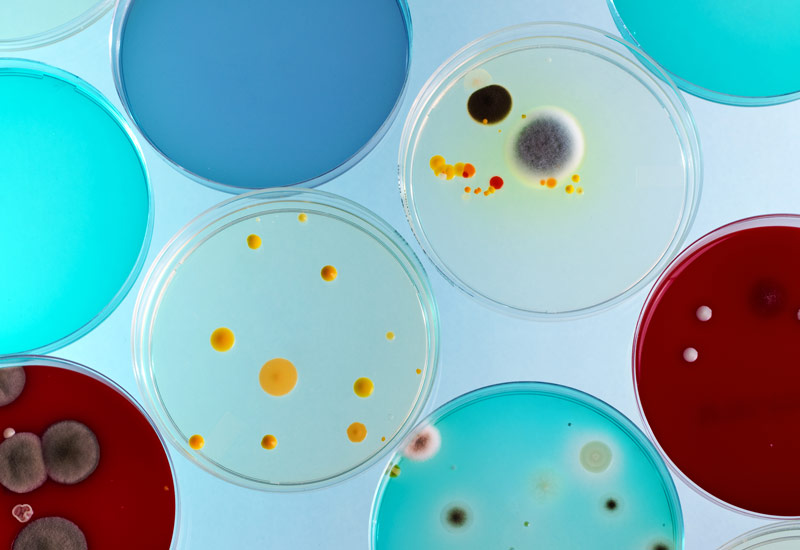
Image for: Our Human Development Pillars

Get the right experience for you. Please select your location and investor type.
IMPORTANT NEWS: Transition of investment management responsibilities
First Sentier Group, the global asset management organisation, has announced a strategic transition of Stewart Investors' investment management responsibilities to its affiliate investment team, FSSA Investment Managers, effective Friday, 14 November close of business EST.

Insights
Articles, research and reports
An affiliate of First Sentier Group
Copyright © 2026 Stewart Investors.